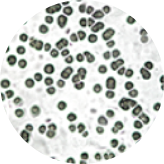

選べる4つのタイプ
-
より自然なかけ姿の
SLIMスリム
追求 -
2018年1月25日発売
目の周りのうるおいを
MOISTモイスト
保つ保湿機能付き -
2018年1月25日発売
ラバーガードが
KIDS&JUNIORキッズ&ジュニア
お子様の目を守る -
2018年1月25日発売
度付きレンズに
BASICベーシック
変更可能
SLIMスリム

フレームカーブを額に沿うように設計し、
普通の眼鏡のようなシルエットに。
シリーズ中、最も自然なかけ姿が叶うタイプです。
2 types 4 colors / 各¥5,000 (+税)
WELLINGTONウエリントン




SQUAREスクエア




よりスリムな見た目に。


MOISTモイスト

ウォーターポケット内臓で
目の周りのうるおいを保つ保湿機能付き。
乾燥が気になる方に。
4 colors / 各¥5,000 (+税)
WELLINGTONウエリントン




-
水のいれ方

ウォーターポケット内のスポンジが
しめる程度に水を垂らす。 -
スポンジの替え方

ウォーターポケットのカバーを開き
新しいスポンジに替える。
高い保湿効果で、
目のまわりの潤いをキープ

-

花粉カットメガネと裸眼の状態を⽐較。
低湿度対応の恒温恒湿槽のチャンバー内に固定した人頭模型を設置。
低温、低湿環境(花粉時期の外環境を再現)における湿度を測定。
※当社調べ/保湿率は環境やメガネのかけ⽅、顔の形などにより異なります。
※MOISTと裸眼の状態を⽐較。
※低湿度対応の恒温恒湿槽のチャンバー内に固定した人頭模型を設置。
低温、低湿環境(花粉時期の外環境を再現)における湿度を測定。
※グラフはMOIST装着後、30分経過後からの10分間を測定したものです。
高い保湿効果のある特殊スポンジを使用
KIDS&JUNIORキッズ&ジュニア

お子様の顔のサイズに応じた、
2つのサイズをご用意しました。
従来よりも肌に自然になじむ色合いになった
ラバーガードが元気に動くお子様の目を守ります。
オプションで度付きレンズへも変更可能です。
2 types 4 colors / 各¥3,000 (+税)
KIDS SIZEキッズサイズ
対象年齢目安:平均的な小学校中学年~高学年(およそ9~12才)




JUNIOR SIZEジュニアサイズ
対象年齢目安:平均的な小学校高学年~中学生(およそ10~15才)




BASICベーシック

度付きのレンズに変更可能。
日常的にメガネを使用している方に。
4 colors / 各¥5,000 (+税)
度付きクリアレンズ ¥7,000(+税)
SQUAREスクエア




医療機関との共同実験による
高い花粉カット効果の実証
-
0% カット
裸眼
裸眼 -
51% カット
 通常メガネ
通常メガネ -
98% カット
 JINS花粉CUT
JINS花粉CUT
花粉カットメガネの着用によって最大98%もの花粉の侵入をカットしていることを確認。花粉は上から飛散するので、通常のメガネ(51%カット)よりもフレーム上部にフードが付いた花粉カットメガネのほうが、花粉の目の表面への付着を防止する効果が高いことがわかりました。また花粉同様に黄砂や大気汚染物質PM2.5の⽬の表⾯への付着や紫外線も防ぎます。
※当社調べ/花粉のカット率は環境やメガネのかけ方、顔の形などにより異なります。
※花粉カットメガネと通常のメガネを比較
※ワセリン塗布カバーガラスの表面に固定した人頭模型をチャンパー内に設置。スギ花粉を噴霧し、カバーガラスへの花粉付着量を光学顕微鏡を⽤いて計測
※実験は両国眼科クリニック深川和己先生が実施・監修
-
耳元の調整方法
-
実証実験
こどもと学ぶ花粉・アレルギー
出張授業を実施!
「こどものうちに花粉から身を守る方法を身につけてほしい。」
JINSでは、そんな想いから身近なアレルギーとの付き合い方を学ぶ出張授業を実施しました。
アレルギーのメカニズムや種類を学習してから、みんなで対策方法を考えます。
体験学習パートでは、実際にJINS花粉CUTをかけていただきました。
-
 千葉県富里市立富里第一小学校
千葉県富里市立富里第一小学校
-
 千葉大学教育学部附属中学校
千葉大学教育学部附属中学校
-
 大網白里市立大網中学校
大網白里市立大網中学校


